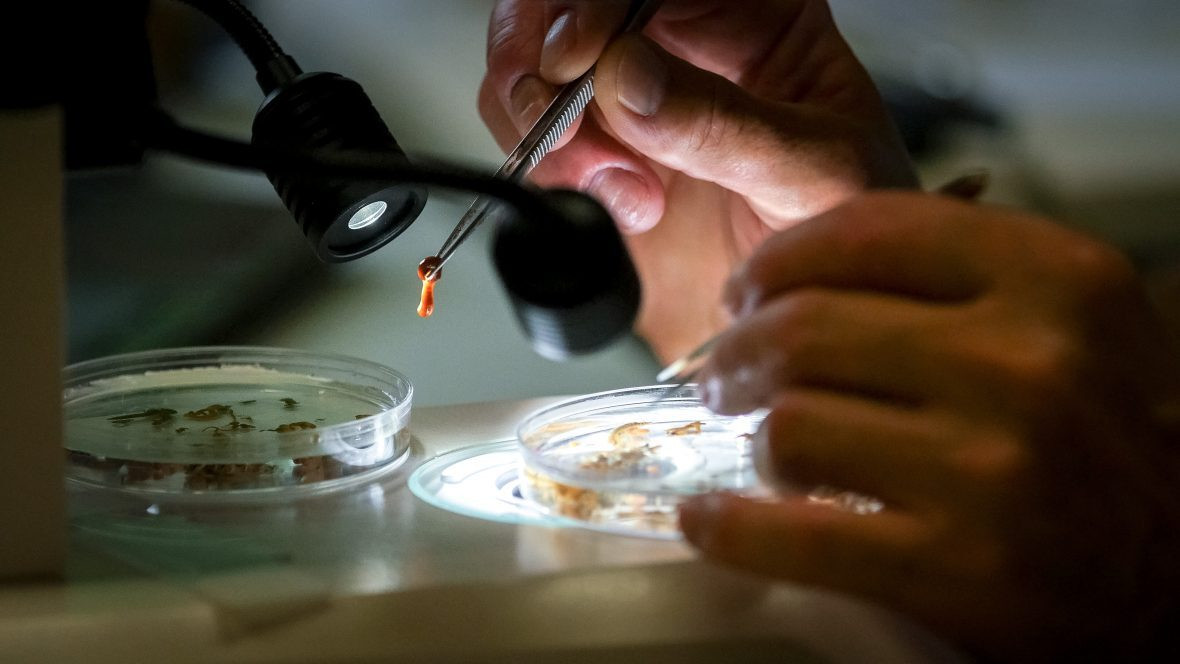
Boosting the Barcode

DNA barcoding has become a standard method for studying biodiversity and has led to the discovery of many new species.
For the last seven years, the Hakai Institute has been a leader in DNA barcoding of marine life. DNA barcoding is the use of a short, standardized region of DNA to identify different species. By sequencing the DNA barcode region from as many species as they can get their hands on, scientists have created a massive reference database—the Barcode of Life Database (BOLD)—for identifying species by their genetic information.
Through large-scale bioblitzes and collaborations with marine scientists and taxonomists, Hakai Institute researchers have contributed thousands of new DNA barcode sequences from historically understudied groups.
“It’s no exaggeration to say that every survey we do uncovers something new,” says Hakai Institute scientist Matt Lemay. “The ocean contains an astonishing diversity of creatures that have received much less attention than terrestrial creatures. Many ocean species are small, cryptic, or live deep down, making them challenging to collect and identify.”